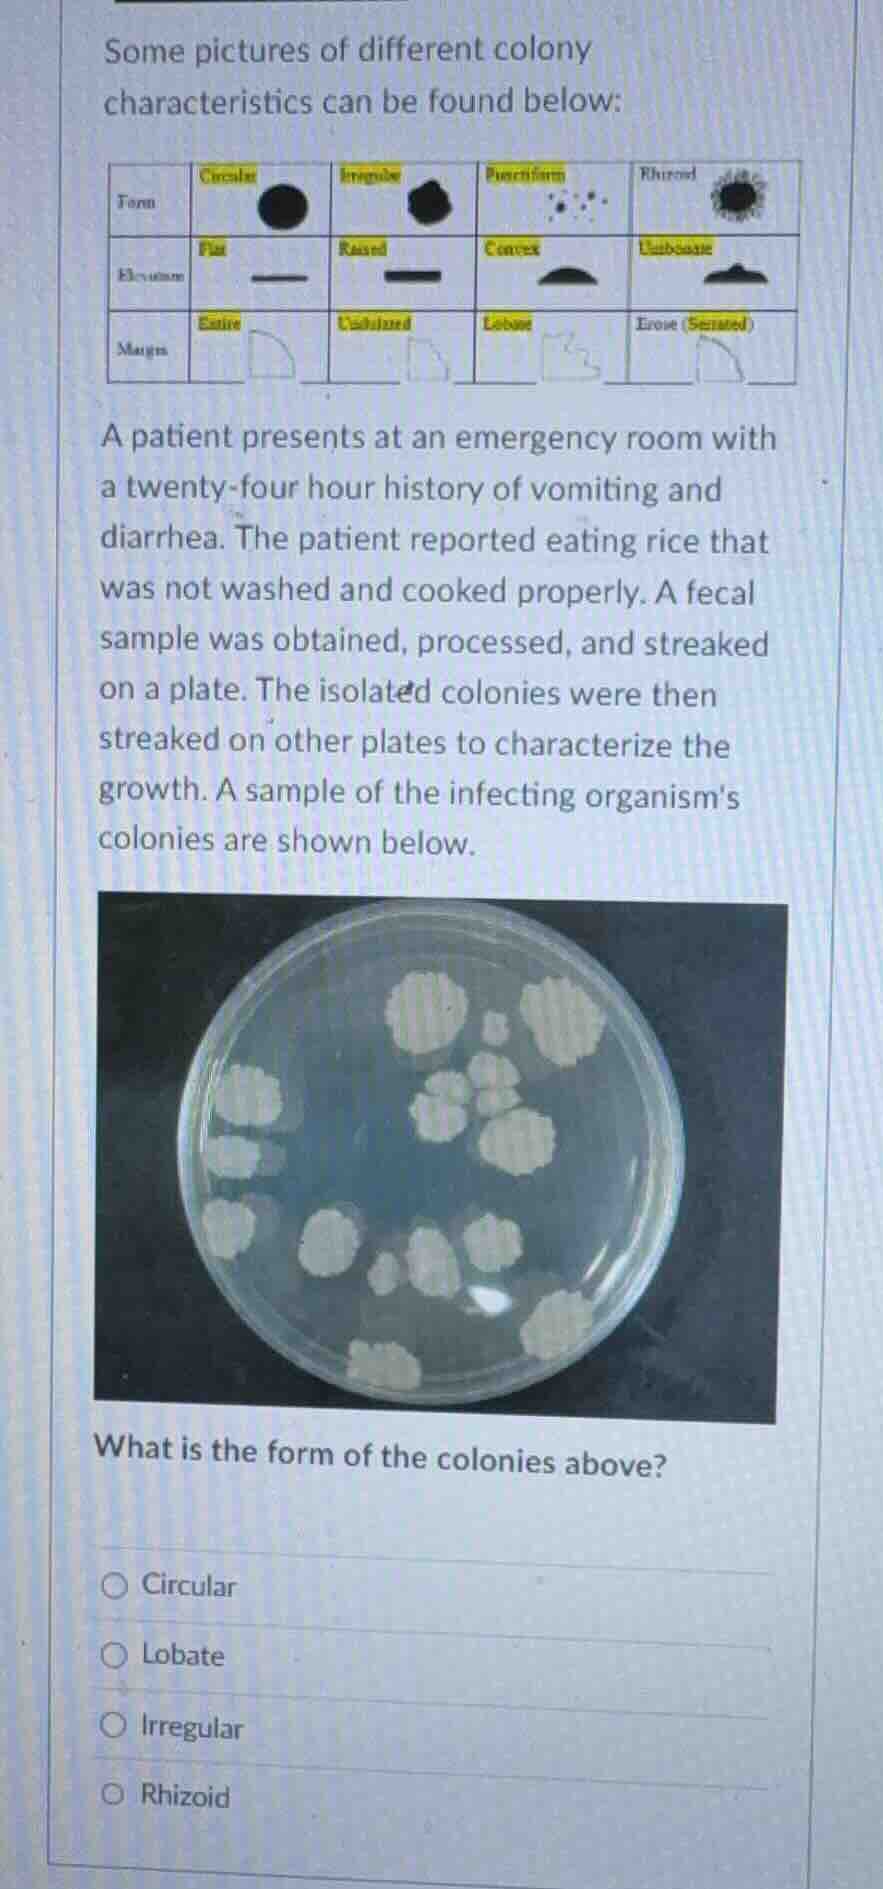
some pictures of different colony characteristics can be found below: a…

QUESTION IMAGE
Question
some pictures of different colony characteristics can be found below: a patient presents at an emergency room with a twenty - four hour history of vomiting and diarrhea. the patient reported eating rice that was not washed and cooked properly. a fecal sample was obtained, processed, and streaked on a plate. the isolated colonies were then streaked on other plates to characterize the growth. a sample of the infecting organisms colonies are shown below. what is the form of the colonies above?
- circular
- lobate
- irregular
- rhizoid
To determine the colony form, we analyze the options. Circular colonies are round and uniform. Lobate has a lobed edge, but the key here is the overall shape. Irregular colonies have non - uniform, irregular shapes. The colonies in the image don't have a regular circular shape, nor the specific features of lobate or rhizoid. The colonies' shape is non - regular, matching the definition of irregular.
Snap & solve any problem in the app
Get step-by-step solutions on Sovi AI
Photo-based solutions with guided steps
Explore more problems and detailed explanations
C. Irregular